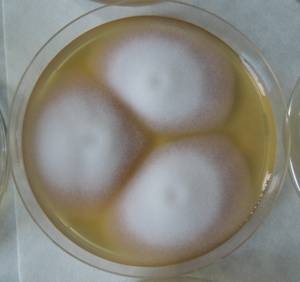
MSU_FS-02272 01, Район Ба Ви муниципалитета Ханой (Ba Vì district of Hanoi), Hanoi (Vietnam)
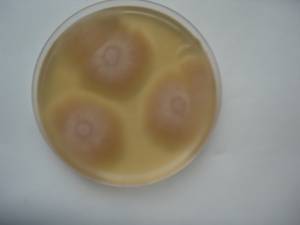
MSU_FS-00949 01, Район Лак Дыонг (Lạc Dương district), Lâm Đồng province (Vietnam)

Total items: 2
Total pages: 1
Organisms
- Specimen ID
- 0000000905348
- Species
- Umbelopsis angularis
- Strain
- MSU_FS-02272
- Place of isolation
- Район Ба Ви муниципалитета Ханой (Ba Vì district of Hanoi), Hanoi (Vietnam)
- Placename
- Ба Ви (Ba Vì commune)
- Specimen ID
- 0000000903774
- Species
- Umbelopsis angularis
- Strain
- MSU_FS-00949
- Place of isolation
- Район Лак Дыонг (Lạc Dương district), Lâm Đồng province (Vietnam)
- Placename
- Да Чаис (Đạ Chais)